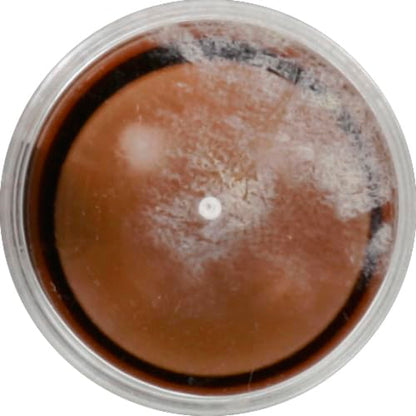

1
/
of
16
wet n wild MegaGlo Makeup Stick, Buildable Color, Me Maple
wet n wild MegaGlo Makeup Stick, Buildable Color, Me Maple
Regular price
$5.99 USD
Regular price
$6.99 USD
Sale price
$5.99 USD
Unit price
/
per
Couldn't load pickup availability
About This
- In one swipe you can get catwalk-ready cheekbones, naturally flushed cheeks or an insanely glowy complexion.
- Toss one of these in your purse or pocket and you’ll be camera-ready in less time it takes to double tap.
- Multi-use sticks that conceal, highlight, contour and add a pop of color to the cheeks. Easy to control design with precise application.
- Available in: Strobe, Contour, Conceal and Blush.
Overview
- Item Form : Stick
- Finish Type : Shimmery
- Coverage : Medium
- Brand : wet n wild
- Color : Call Me Maple